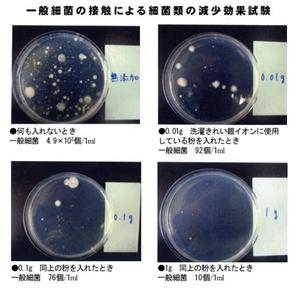
�ߋ��ō��̎��M��I���E���̒��p���[�����󂫂ꂢ ��C�I���v���X

洗濯きれい 銀イオンプラス
 | |||||
|
●前回、各業界にセンセーショナルを巻き起こした『トイレきれい銀イオンプラス』の“洗濯きれい”バージョンがついに完成! ●SACチタンボール×ナノシルバーの無敵パワー☆ ●ニオイに汚れに、強力アタック☆大腸菌郡数もゼロに!! ●使うほどに洗濯槽もピッカピカ! ●地球に優しく、安全性も◎。半永久的に使用OKだから、お財布も大助かり?♪ | |||||
| |||||
“きれいシリーズ”ファンのみなさん、お待たせしました!前回、各業界にセンセーショナルを巻き起こした、進化した『トイレきれい銀イオンプラス』の“洗濯きれい”バージョンがついに完成しましたっ☆今までの洗濯きれいもすごかったけど、NEWバージョンはその足元にも及びません。なんてったって、『世界初』のパワーが詰まっているんです。正直、これは期待以上のパワーです。はっきり言って、これは事件です!!!
■SACチタンボールの秘密。
まずはいつもの「光触媒」の説明から。光触媒は本来、紫外線がなければ発生しないパワー。でもこのSACチタンボールは、国際特許公開の技術により、暗所でもパワーを発揮!細菌・雑菌を分解し、酸素と二酸化炭素に変化。すなわち、あらゆる有機物を分解し、ニオイにアタック!さらに、細かい水の分子が汚れを強力に剥ぎ取ってくれちゃいます!自然の法則を利用しているから環境にも優しいし、面倒な手間は一切ナシ!洗濯機にこの洗濯きれいをポンッと入れるだけでイイんだから、凄いでしょ♪
■世界初!ナノシルバーの秘密。
最近、巷で何かと話題の“銀(Ag)パワー”。洗剤や消臭剤、制汗剤に使用されていることからも、その実力は明らかですよね。その“銀”をナノサイズ(1ナノ=10億分の1メートル)に粒子化したものをSACチタンボールに圧入。今、大手企業がこぞって研究を進めている“ナノ技術”を、チタンボールに組み入れたのはこの「きれいシリーズ」が世界初です!!
■実験結果に…唖然!
SACチタンボールにナノシルバーパワーが組み合わされば、これはもう無敵でしょ。もちろん、見た目の汚れだけに強いわけじゃありません!なんと、細菌や悪臭ものきなみ撃退。大腸菌数はほぼゼロに。カビの抑制にもパワーを発揮!
■洗濯槽もピッカピカ☆
洗濯槽のお掃除って、ついつい見落としがち。うようよカビが繁殖している洗濯槽で洗ってしまったら、当然衣類にもカビや菌が…。何か肌がカユイ、または衣服に何故かカビが生えた、という人は洗濯槽に問題があるのかも。この「洗濯きれい 銀イオンプラス」なら、洗うほどに洗濯槽もピカピカするし、洗濯物のニオイもしっかりガード!生乾きのイヤーなニオイも半減されるから、とっても大助かり?☆
■ほかにも嬉しいことがいーっぱい!
☆洗浄パワー…白はさらに白く、色物もより鮮やかに!抗菌パワーもあるから清潔に、ふっくら仕上がります。皮膚のデリケートな方や、赤ちゃん、お年寄りの方も安心です。
☆経済性…洗剤・柔軟剤はほとんど不要だし、すすぎも1回ですむから水道代・電気代ともに節約できちゃいます!強力な汚れには洗剤を入れたほうがいい時もあるけど、軽い汚れなら洗剤を使わなくても大丈夫♪
☆浄化パワー…槽内や槽の裏側の雑菌にアタックし、使い続けるほどに黒カビを除去。
☆半永久的に使用可能…半永久的にパワーが持続!時々、自然光に当てるとさらにパワーUPしますよ。
はっきり言って、もうこれ以上の「洗濯きれい」は出来ないかもしれません。それくらいの自信作!これは絶対、買って損なし。ご近所さんにも是非オススメしてくださいね?♪
 |
 |
|
 |
○商品名:NEW洗濯きれい
○サイズ:約縦12×横11×高4cm
○重量:約115g
○材質:
浮き子/ポリプロピレン
装填部/ポリエステル
機能部/SACチタンボール
○生産国:日本









